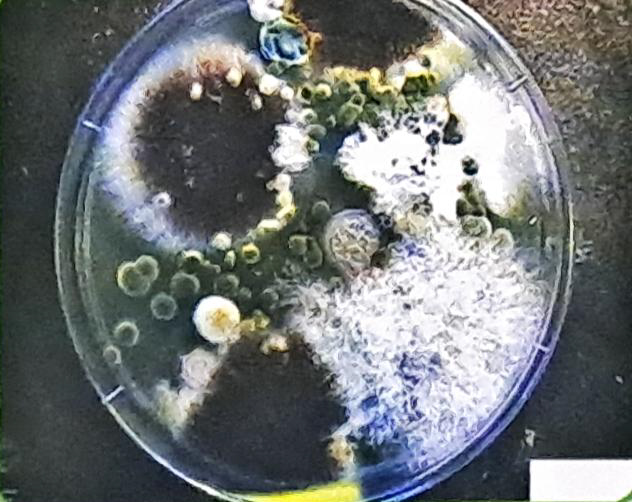
Air Testing Cassettes

Air Condition(HVAC) System Cleaning
Professional HVAC Cleaning Services
NADCA certified cleaning services following ACR 2021 standards for complete air duct system cleaning and sanitization
Heating Ventilation and Air Conditioning Systems need to be cleaned periodically as they perform the same function like our lungs in the body. Bacteria and mold spores are only able to grow where nutrients are provided along with moisture and oxygen, the nutrients are provided from dirt, dust and debris, animal dander inside of the air ducting which in all probability has never been cleaned since it was installed. This is also the cause of the musty odor present in the rooms.
Dirty A/C systems contribute very heavily to a variety of allergy related problems including frequent coughs and colds, post operational infections, asthma, skin rash, and various other allergy and allergy related illnesses. To eliminate the high-risk area of infection and allergens the system is required to be properly cleaned and sanitized regularly.
Muscat EPSCO LLC cleans the complete air duct system to the American standard ACR 2021. This standard produced by NADCA (National Air Duct Cleaners Association) is used worldwide to ensure systems are professionally cleaned. We are the only company in Oman, with staff Certified by NADCA to clean HVAC systems to NADCA standards.
Cleaning Robot
Key Benefits of Clean HVAC Systems
Increased Productivity
Healthier people make better workers and reduce absenteeism, improving overall employee productivity.
Reduced Housekeeping Costs
The HVAC system is not pumping dust and dirty air into the occupied space, reducing cleaning needs.
Increased Airflow
Air moves unobstructed by debris buildup, blowers and fans do not need to cycle as long or as often.
Energy Saving
Motors and drives do not work as hard, resulting in less energy consumption by the system.
NADCA Certified
We are the only company in Oman with staff certified by NADCA to clean HVAC systems to NADCA standards.
Robotic Inspection & Cleaning
We use robotic inspection and cleaning techniques for surveys, inspection, and quality assurance purposes.
ACR 2021 Standard
Complete air duct system cleaning following the American standard ACR 2021 produced by NADCA.